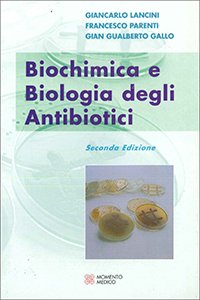

Descrizione
Biochimica e biologia degli antibiotici
25,82 €
Biochimica e biologia degli antibiotici
Solo 1 pezzi disponibili
Fondamenti di agopuntura e medicina cinese
I fondamenti della medicina cinese
Cure palliative in medicina generale. Aspetti etici relazionali, clinici organizzativi delle cure palliative domiciliari
15,00 €
COFANETTO Robbins e Cotran (2 volumi) Basi Patologiche delle Malattie + Test + Klatt - Atlante di anatomia patologica
Introduzione all'inferenza statistica senza (troppo) sforzo
Trattato di Intradermo Terapia Distrettuale - MESOTERAPIA
La Guardia Medica 2025. NUOVO. SPEDIZIONE GRATUITA
Semeiotica e Metodologia Clinica

Recensioni
Ancora non ci sono recensioni.